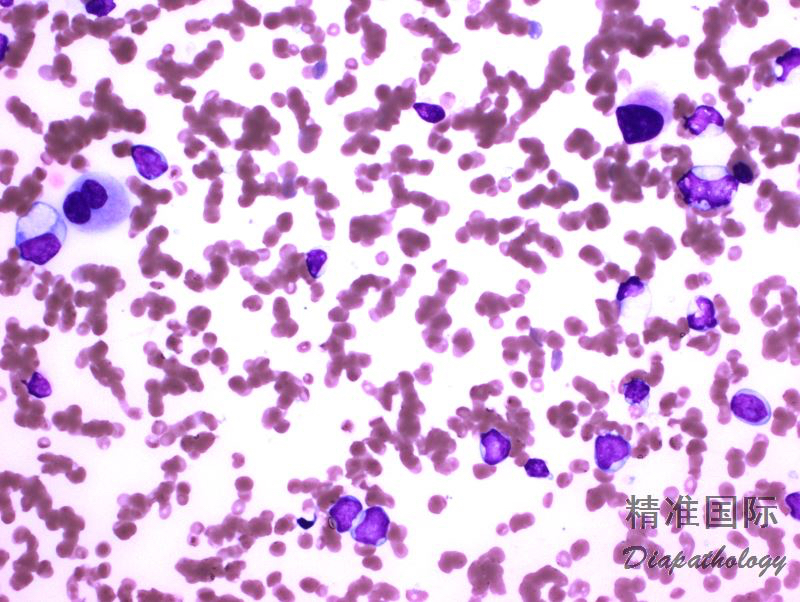

急性髓系白血病伴骨髓增生异常相关改变
Acute Myeloid Leukemia with Myelodysplasia-Related Changes
概述:
急性髓系白血病伴骨髓增生异常相关的改变系急性髓系白血病(外周血或骨髓中母细胞 ≥20%)并至少符合以下标准之一:多系至少 50%细胞有异型增生,有 MDS 或 MDS/MPN 病史,或具有骨髓增生相关的细胞遗传学异常。
诊断要点:
- 主要见于老年人,表现为严重全血细胞减少。此型占所有 AML 病例的 24-35%。有的病例(特别是从 MDS 转化的病例和儿童)母细胞较低(20-29%),其临床病程表现可能更类似于 MDS 而不是 AML。
- 诊断标准,需同时满足以下三项(WHO 2107 版):
(1) 外周血或骨髓中母细胞 ≥20%
(2) 有下列任何一项
-MDS 或 MDS/MPN 病史
-MDS 相关细胞遗传学异常
-多系异型增生
(3) 下列两相均不存在
-因其它疾病有过细胞毒或放射线治疗史
-重现性细胞遗传学异常(AML 伴重现性细胞遗传学异常所特有的遗传学改变)
对于原发性 AML 伴 NPM1 或 CEBPA 双等位突变的病例,仅存在多系异常不足以诊断 AML 伴骨髓异型增生相关改变。
形态学:外周血或骨髓中髓系母细胞增高(≥20%),多系异型增生,如髓系发育异常可表现为少颗粒或低分叶粒细胞、红系发育异常可见巨幼细胞样改变或多核、巨核发育异常表现为微巨核或不分叶等。如仅根据形态学(发育异常)诊断 AML-MRC,发育异常细胞的比例至少要达 50%,且至少累及两系。对于发育异常细胞少于 50%的病例(包括那些非原始细胞很少的病例),需要有细胞遗传学证据或有 MDS 或 MDS/MPN 病史才能诊断。
免疫表型:抗原表达不一。 -7del(7q)和-5del(5q)病例 CD34. TdT 表达率高,也有 CD7 表达的报道。MDS 转化来者仅部分细胞表达 CD34,并有低表达 CD38. HLA-DR(干细胞相关表型);母细胞常表达 CD13. CD33,也可异常表达 CD56. CD7,MDR1 表达率也增加。有报道母细胞表达 CD14 者预后不良。
遗传学:与 MDS 相似,并常见复杂核型,最常见的是-7del(7q)和-5del(5q)及累及 5q 的非平衡易位。+8. del(20q)或-Y 不足以诊断 AML-MRC。

鉴别诊断:
- 高级别 MD 或 MDS/MPN : 常有多系异型,或同时有 MDS 相关遗传学异常,但母细胞<20%。
- 治疗后相关急性髓系白血病: 常有多系异型,并伴遗传学异常,但如有细胞毒治疗史,则应优先诊断为治疗后相关急性髓系白血病。
- 急性髓系白血病- 非特指: 如母细胞 ≥20%,伴多系异型或 MDS 相关遗传学改变(符合三项标准),则应优先诊断为急性髓系白血病伴骨髓增生异常相关的改变。
- AML 伴重现性遗传学异常: 有些表现为多系异型,但只要存在 WHO 定义的重现性遗传学异常,如 t(6;9)、t(3;3),应优先诊断为 AML 伴重现性遗传学异常。
- AML 伴 NPM1 突变或 AML 伴双等位 CEBPA 突变: 这类白血病多为正常核型,也无 MDS 病史, 但可以有多系发育异常,不应诊断为 AML-MRC,应优先诊断为 AML 伴 NPM1 突变或 CEBPA 双等位突变。但是,如有 MDS 相关的细胞遗传学异常(-9q 除外),则应优先诊断为 MDS-MRC。 因此,对于没有细胞遗传学异常、没有 MDS 或 MDS/MPN 病史的 AML 伴形态多系发育异常的病例,应检测有无 NPM1 突变或 CEBPA 双等位突变,以除外预后较好的 AML 伴 NPM1 突变或 AML 伴双等位 CEBPA 突变。
预后:
预后一般都不良。细胞遗传学异常与预后关系密切,形态学多系异常也与预后不好有关。由 MDS 转化的母细胞较低的 AML-MRC 临床侵袭性相对较低,那些母细胞在 20-29%的病例临床表现可能更类似 MDS。
